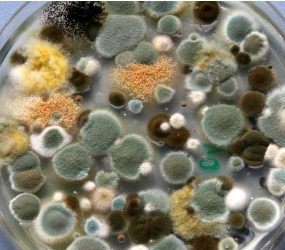
霉菌污染原因分析
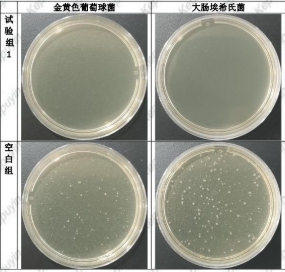
抗/抑菌剂检测

您的行业

快速申请办理
称呼:
*
电话: *
备注:
电话: *
备注:
订单提交后,10分钟内,我们将安排工作人员和您联系!
联系方式
北京市华材检测有限公司
电话:18001161763
邮箱:zjzjtest@foxmail.com
地址:北京市丰台区星火路1号院2号楼-2至24层101内4层406室